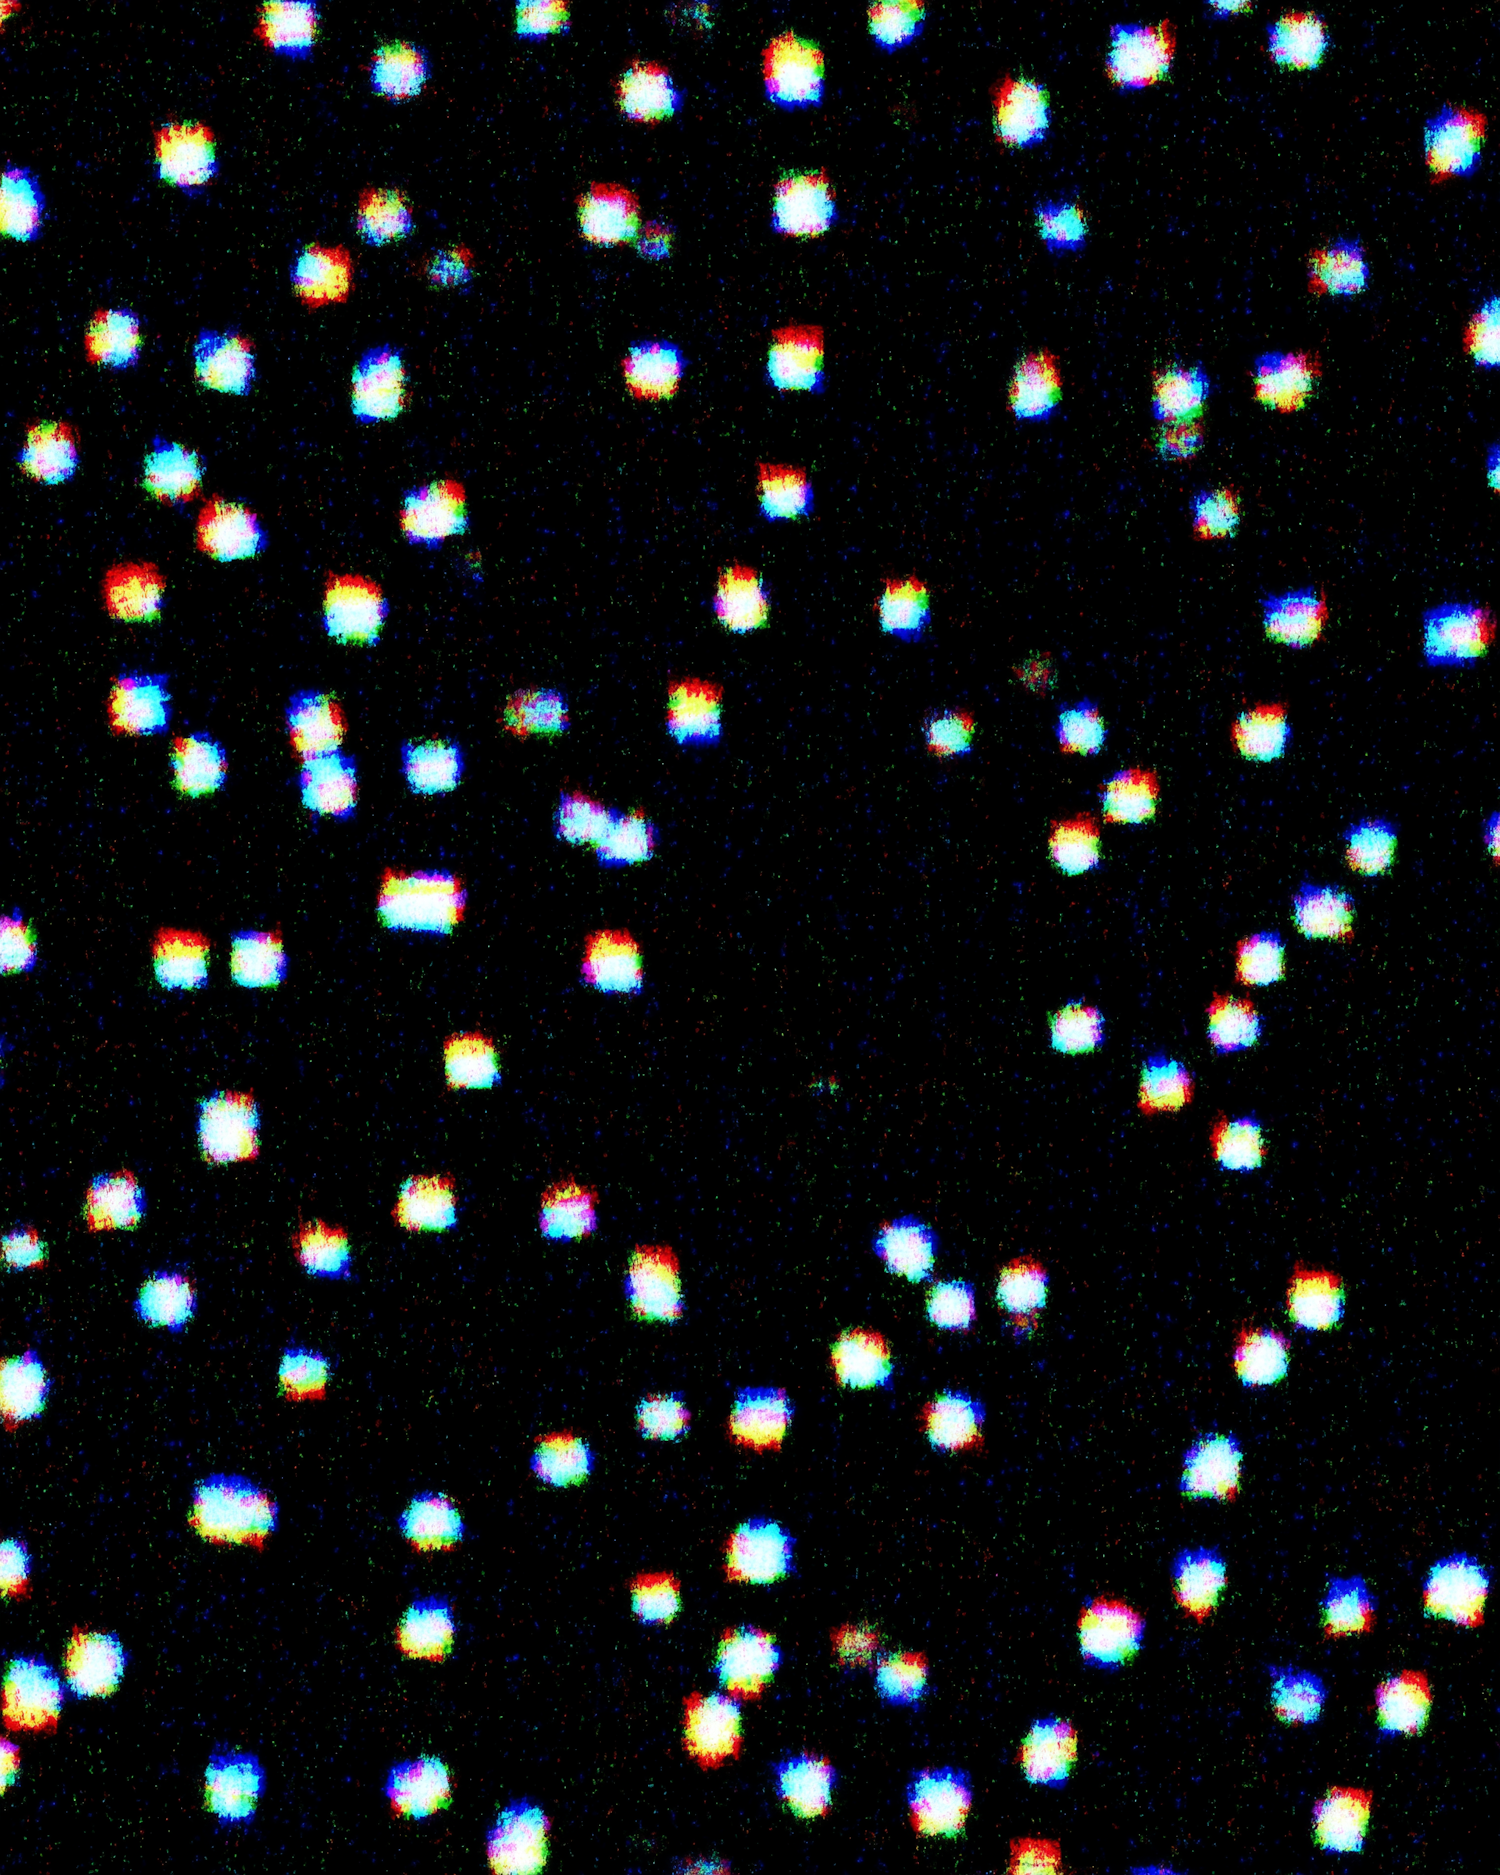

Colorful Starry Night
Colorful glowing dots scattered on a black background, resembling a pixelated starry night with a vibrant rainbow effect.
Colorful glowing dots scattered on a black background, resembling a pixelated starry night with a vibrant rainbow effect.
108
Views
23
Downloads
5
Collected